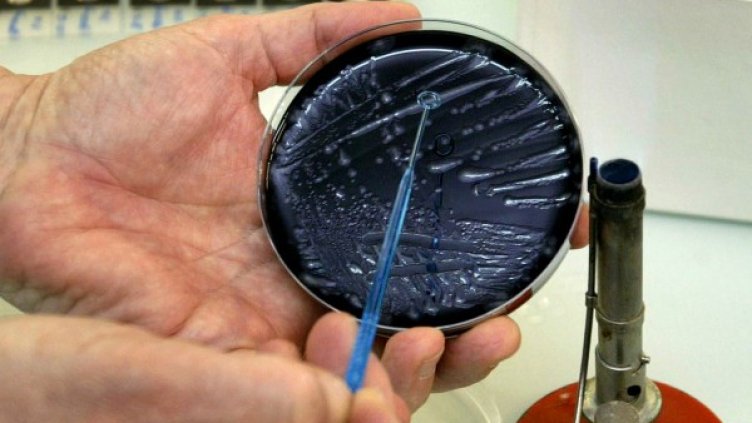
Снимка: Reuters

Двама британски туристи починаха от т.нар. легионерска болест, докато са били на почивка в Слънчев бряг, а други двама, отседнали отново в градчето, са заразени, но се възстановяват.
Каква обаче е тази болест и как можем да се заразим с нея? Лекува ли се и как да се предпазим? На тези въпроси отговориха от Министерството на здравеопазването, малко след като информацията за трагедиите в Слънчев бряг заляха медийното пространство.
"Ежегодно в Европа се регистрират по около 10 000 случая, като водещи страни по брой заболявания са Франция, Германия, Италия и Испания", обясняват от министерството.
Заболяването засяга преди всичко хора в напреднала възраст, пушачи, с хронични белодробни болести, с компрометирана имунна система и/или с хронични заболявания.
Основните начини за заразяване са чрез инхалиране на легионелите с водни капчици от душови уредби, охладителни кули, декоративни фонтани, системи за охлаждане чрез водна мъгла и др.
Заболяването най-често предизвиква тежки пневмонии, като смъртността достига до 10 %. При диагностициране в начална фаза заболяването се лекува ефективно с антибиотични препарати.
Предпазните мерки включват поддържане на добра хигиена на водопроводни и душови инсталации, климатици с водна циркулация и други водни съоръжения. За целта се използва механично почистване, химични средства, дезинфекция с гореща вода (“термален“ шок). Всички тези мерки ежегодно се предписват от органите на общественото здраве и изпълнението им се проверява от здравните инспектори на РЗИ.
Какво се случва в Слънчев бряг и защо точно там са се заразили британците?
Според Министерството на здравеопазването хотелите, както там така и по цялото Черноморие, подлежат ежегодно на планов и извънпланов контрол от РЗИ-Бургас, в това число и наличие на легионели.
"Пробите, взети от конкретния хотел в Курортен комплекс "Слънчев бряг" преди началото на летния туристически сезон 2019, са отрицателни", категорични са от ведомството.
От там допълват, че в случай на съмнение за легионерска болест на територията на страната, Регионалните здравни инспекции издават предписания с конкретни противоепидемични мерки - да се извършва механично почистване на съоръженията и водоснабдителните системи и климатичните инсталации; да се извършва дезинфекция чрез хиперхлориране; да се провежда дезинфекция чрез „термален“ шок – с повишена температура на водата 70-80 градуса, перманентно да се поддържат високи стойности на топлата вода и т. н.
"Съгласно правилата на работа на Европейската система за надзор на Легионерската болест (ELDSnet), в която България членува, цялата информация по отношение на заболелите лица, както и резултатите от проведените изследвания на хора и среда, са конфиденциални", завършва писмото на Министерството на здравеопазването.
Това се случи Dnes, за важното през деня ни последвайте и в Google News Showcase.

Кадър на деня за 4 юли
Кадър на деня за 4 юли  От Макрон до Моди: Правителствата разгъват червен килим за гигантите в изкуствения интелект
От Макрон до Моди: Правителствата разгъват червен килим за гигантите в изкуствения интелект  Путин подписа закон за данъчни промени в подкрепа на руския пазар на горива
Путин подписа закон за данъчни промени в подкрепа на руския пазар на горива  Местните банки ще дадат силен тласък на търговията с криптовалути в Германия
Местните банки ще дадат силен тласък на търговията с криптовалути в Германия  В Австрия беше пуснат в експлоатация нов суперкомпютър за 36 млн. евро
В Австрия беше пуснат в експлоатация нов суперкомпютър за 36 млн. евро  Жадната за енергия Азия вече си взема поуки от кризата в Иран
Жадната за енергия Азия вече си взема поуки от кризата в Иран 
 Звездите, които присъстваха на сватбата на Тейлър Суифт и Травис Келси
Звездите, които присъстваха на сватбата на Тейлър Суифт и Травис Келси  Явор Гечев за санкциите срещу Русия: Българският интерес е защитен
Явор Гечев за санкциите срещу Русия: Българският интерес е защитен  Откриха тялото на изчезналото в река Струма дете
Откриха тялото на изчезналото в река Струма дете  Централна емисия
Централна емисия  Централна емисия
Централна емисия  Най-магнетичните и впечатляващи зодии
Най-магнетичните и впечатляващи зодии 
 Нова сензация на "Уимбълдън": Елена Рибакина също отпадна още в третия кръг
Нова сензация на "Уимбълдън": Елена Рибакина също отпадна още в третия кръг  Славия обърна Септември София – 3:2
Славия обърна Септември София – 3:2  Локомотив Пловдив победи Арда Кърджали в контрола
Локомотив Пловдив победи Арда Кърджали в контрола  Карло Анчелоти отвърна на критиците: Само сър Алекс Фъргюсън е по-квалифициран да ме съди
Карло Анчелоти отвърна на критиците: Само сър Алекс Фъргюсън е по-квалифициран да ме съди  Нейтън Аке напусна Манчестър Сити и подписа с Фенербахче след шест години и 12 трофея
Нейтън Аке напусна Манчестър Сити и подписа с Фенербахче след шест години и 12 трофея  Лудогорец и Ботошани не се победиха – 2:2
Лудогорец и Ботошани не се победиха – 2:2 
 Дневен хороскоп за 5 юли, неделя
Дневен хороскоп за 5 юли, неделя  Поверия за ангелската дата 7/7
Поверия за ангелската дата 7/7  Пухкави пикантни сиренки
Пухкави пикантни сиренки  3 зодии с голям късмет в седмицата 6 – 12 юли 2026
3 зодии с голям късмет в седмицата 6 – 12 юли 2026  Седмична нумерологична прогноза за 6 – 12 юли
Седмична нумерологична прогноза за 6 – 12 юли  Хумус в ориенталски стил
Хумус в ориенталски стил 
 продава, Четиристаен апартамент, 82 m2 Варна, Владиславово, 151999 EUR
продава, Четиристаен апартамент, 82 m2 Варна, Владиславово, 151999 EUR  продава, Двустаен апартамент, 63 m2 Бургас област, к.к.Слънчев Бряг, 71000 EUR
продава, Двустаен апартамент, 63 m2 Бургас област, к.к.Слънчев Бряг, 71000 EUR  продава, Двустаен апартамент, 60 m2 Бургас област, к.к.Слънчев Бряг, 99000 EUR
продава, Двустаен апартамент, 60 m2 Бургас област, к.к.Слънчев Бряг, 99000 EUR  продава, Къща, 91 m2 Добрич област, с.Царичино, 155000 EUR
продава, Къща, 91 m2 Добрич област, с.Царичино, 155000 EUR  продава, Тристаен апартамент, 103 m2 Бургас област, гр.Айтос, 118450 EUR
продава, Тристаен апартамент, 103 m2 Бургас област, гр.Айтос, 118450 EUR  продава, Многостаен апартамент, 135 m2 Бургас област, гр.Айтос, 223776 EUR
продава, Многостаен апартамент, 135 m2 Бургас област, гр.Айтос, 223776 EUR 
 Може ли недоволството в Русия да прерасне в революция?
Може ли недоволството в Русия да прерасне в революция?  Скритата цена на изкуствения интелект: центровете за данни изразходват много повече вода, отколкото показват отчетите
Скритата цена на изкуствения интелект: центровете за данни изразходват много повече вода, отколкото показват отчетите  Българската икономика запазва растежа си, но бюджетът и инфлацията остават основни рискове
Българската икономика запазва растежа си, но бюджетът и инфлацията остават основни рискове  Детската смъртност в България спада, но остава над средното за ЕС
Детската смъртност в България спада, но остава над средното за ЕС  Какво ще е времето утре?
Какво ще е времето утре?  Авария оставя без вода един район във Варна
Авария оставя без вода един район във Варна 
 Еверест отстъпва: Кои са най-опасните върхове в света?
Еверест отстъпва: Кои са най-опасните върхове в света?  Преди 400 г. художник е изобразил феномен, който науката e потвърдила едва наскоро
Преди 400 г. художник е изобразил феномен, който науката e потвърдила едва наскоро  Малка бактериална тайна може да доведе до по-добри лекарства срещу рак
Малка бактериална тайна може да доведе до по-добри лекарства срещу рак  НАСА с необичайно обещание: Футболна топка ще лети до Луната, ако САЩ спечелят световното първенство
НАСА с необичайно обещание: Футболна топка ще лети до Луната, ако САЩ спечелят световното първенство  Каква ще бъде съдбата на Слънчевата система след смъртта на Слънцето
Каква ще бъде съдбата на Слънчевата система след смъртта на Слънцето  Ще успее ли НАСА да изстреля спасителна космическа мисия за „Нийл Герелс Суифт“
Ще успее ли НАСА да изстреля спасителна космическа мисия за „Нийл Герелс Суифт“ 










